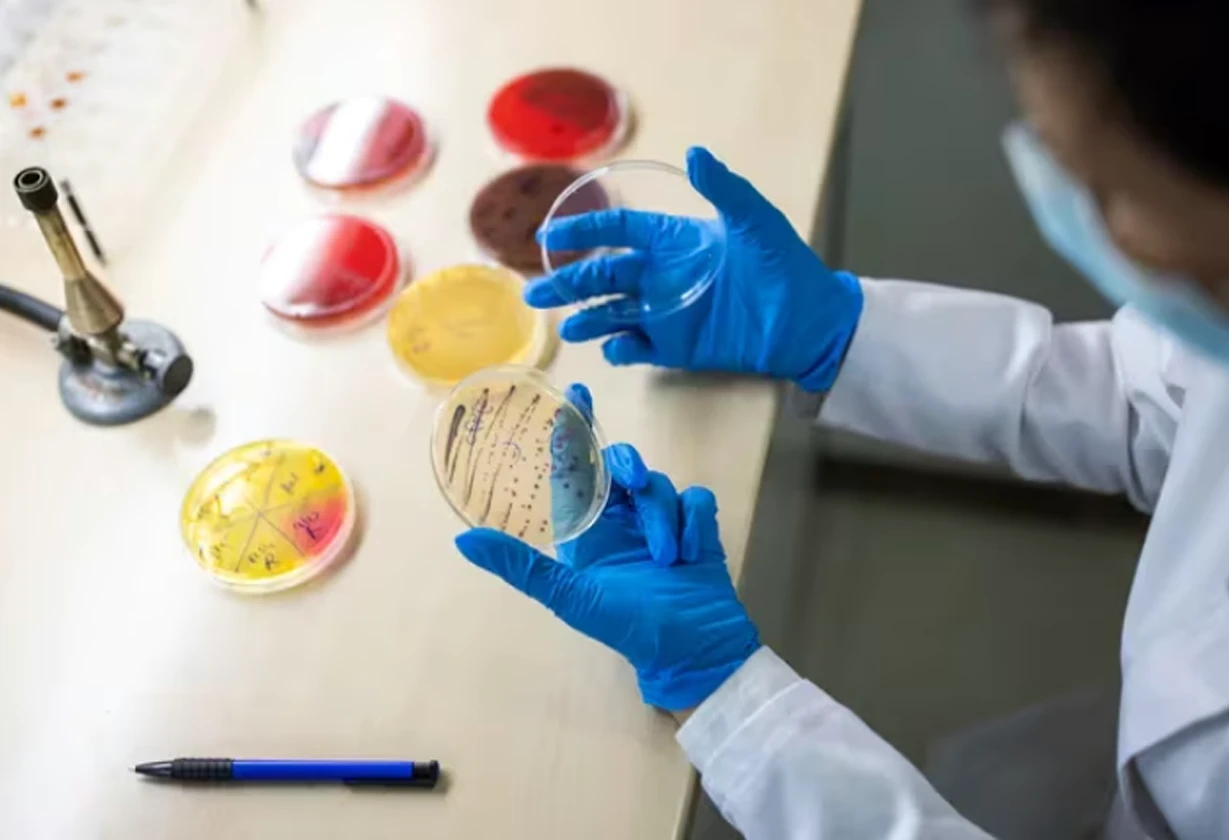

La Pampa refuerza la prevención del SUH con campañas, protocolos de diagnóstico rápido y recomendaciones para reducir riesgos en la comunidad.

La Pampa refuerza la prevención del SUH con campañas, protocolos de diagnóstico rápido y recomendaciones para reducir riesgos en la comunidad.

El Síndrome Urémico Hemolítico afecta a 300 niños al año en Argentina. Conoce sus síntomas y cómo prevenirlo con higiene y cocción adecuada.

Advertencia sanitaria – Especialistas alertan sobre el aumento de casos de Síndrome Urémico Hemolítico en Chubut y recomiendan medidas de prevención.
Cada 19 de agosto, Argentina conmemora el Día Nacional de la Lucha contra el Síndrome Urémico Hemolítico

El Ministerio de Salud de la provincia de Córdoba ha confirmado la trágica muerte de tres niños a causa del Síndrome Urémico Hemolítico